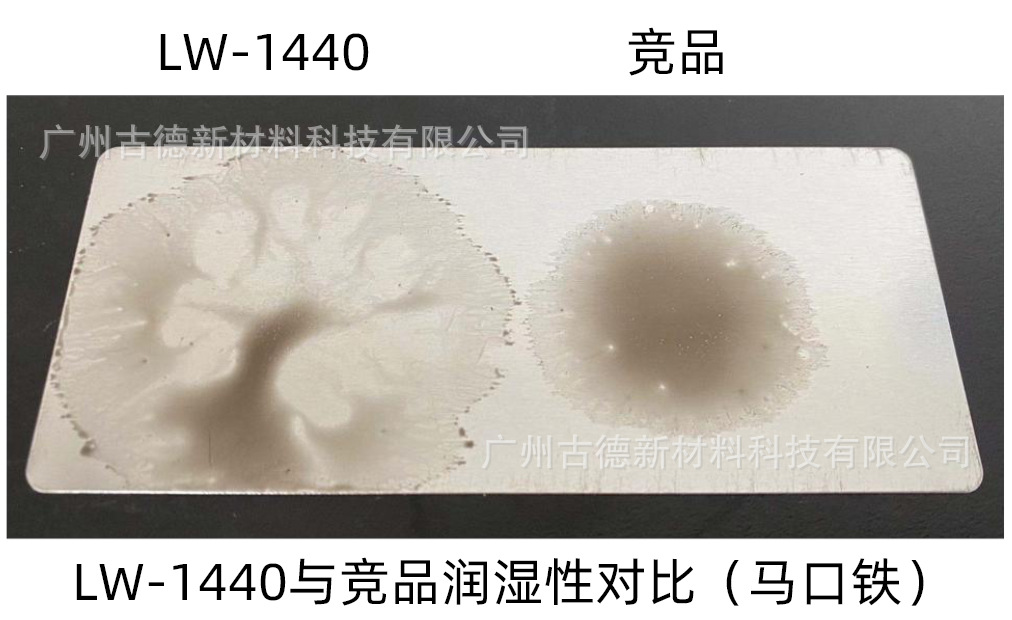

水性潤濕劑是一種表面活性劑,其結構一般是由親水基團和親油基團組成,分子的形態以及分子量都影響其性質,水性潤濕劑的HLB越高,親水型越高,潤濕劑的親水基團會影響其溶解度,從而進一步影響膠束的形成,溶解度越大,臨界膠束濃度越高。而親油基團的疏水作用則降低表面張力,影響膠束的形成,其對溫度的敏感程度和受影響性質的變化也不同。
潤濕劑在涂料體系中扮演的先鋒隊角色,可以搶先到達底材表面進行“鋪路”,然后成膜物質就可以順著潤濕劑走過的“路”進行鋪展。在水性體系中,潤濕劑非常重要,因為水的表面張力很高,達到72達因,比底材的表面張力要高得多,加了潤濕劑后,水性涂料就能輕易在底材上鋪展流動。

潤濕劑的潤濕能力一般分為動態表面張力和靜態表面張力。動態表面張力是指潤濕劑潤濕底材的速度,靜態表面張力是潤濕底材的能力。古德的LW-1440,LW-1465等采用雙子潤濕技術,具有低的動態表面張力,低氣泡,潤濕性能和滲透性能優異,而且不影響重涂和涂膜附著力,已廣泛用于水性和UV體系的涂料油墨中。

古德的潤濕劑除了有良好的潤濕性和滲透性,分子帶有去污能力強的基團分支結構,提供很強的抗污染能力,對脫模劑或是油脂污染底材引致的油窩縮孔有特效。